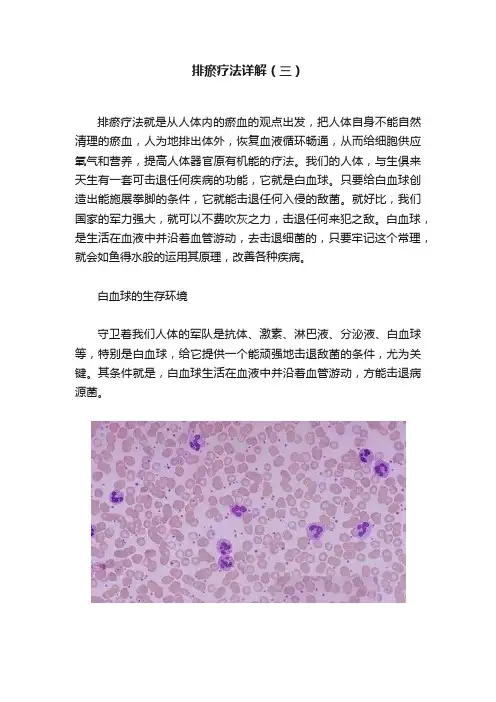

心天排瘀疗法的理论依据.doc
- 格式:doc
- 大小:41.54 KB
- 文档页数:8
排瘀疗法详解(三)排瘀疗法就是从人体内的瘀血的观点出发,把人体自身不能自然清理的瘀血,人为地排出体外,恢复血液循环畅通,从而给细胞供应氧气和营养,提高人体器官原有机能的疗法。
我们的人体,与生俱来天生有一套可击退任何疾病的功能,它就是白血球。
只要给白血球创造出能施展拳脚的条件,它就能击退任何入侵的敌菌。
就好比,我们国家的军力强大,就可以不费吹灰之力,击退任何来犯之敌。
白血球,是生活在血液中并沿着血管游动,去击退细菌的,只要牢记这个常理,就会如鱼得水般的运用其原理,改善各种疾病。
白血球的生存环境守卫着我们人体的军队是抗体、激素、淋巴液、分泌液、白血球等,特别是白血球,给它提供一个能顽强地击退敌菌的条件,尤为关键。
其条件就是,白血球生活在血液中并沿着血管游动,方能击退病源菌。
[概括] :◎ 清净血液◎ 恰当的供应氧气与营养成分◎ 疏通血管,保障白血球漂移白血球生存在血液中,靠沿着血管游动去击退敌菌。
只要疏通了被堵的血管,白血球就可以接近该部位并杀灭病菌,从而不用药就可自愈。
已知血管被堵的直接原因是瘀血,利用排瘀疗法直接排出瘀堵部位的瘀血,疗效胜过用药一倍以上。
排瘀操作须知1、经专业、权威的职业培训后再开始排瘀;2、首先一定要根据顾客的身体状况,经过认真考虑制定一套相应的调理方案,对疾病的发展和转归都要做到心中有数;3、对于饥饿、疲劳、精神高度紧张以及晕车的患者,宜先进食、休息、解除思想顾虑,等心情好后再排瘀;4、准备好所使用排瘀工具;5、掌握排瘀的准确穴位,不要随便移动排瘀的位置;6、为了您的健康,请勿与他人共用一套排瘀工具;7、严格按卫生部门的消毒流程操作;8、操作时要注意观察,多询问病人,如出现不良状况,立即让病人平卧,多饮开水、紫竹盐、蜂蜜水;9、排瘀后嘱咐患者勿暴怒、劳累、饥饿、惊恐,要安静休息,进食有营养的食品,以促使身体的康复;10、排瘀后避免肢体接触冷水,不宜呆在温度过低的环境中,温度太低影响机体的神经调节功能,又可使血管出于收缩状态,不利血液循环的正常运行;11、排瘀后如病人出现疲倦无力,轻微的头晕、头痛、嗜睡,服用紫竹盐,几天后症状即可消失;12、根据病人的病情、体质等情况确定下一次的排瘀时间;13、需服用紫竹盐。

心天泻血排淤疗法疑点答疑【温馨提示】定期义诊:颈肩腰腿痛、类风湿、痛风、头疼、失眠、糖尿病、前列腺、乳腺增生、子宫肌瘤、月经不调、月子病产后风、中风偏瘫半身不遂等;每月两个免费调理名额;先到先得,不容错过。
供应韩国心天泻血罐,泻血笔,泻血针,泻血教材,58个最新版穴位图等泻血相关产品;1、心天泻血排瘀疗法是做什么的?心天泻血排瘀疗法是将血液中的由细胞新陈代谢产物、毒素、失去活力的血液细胞等组成的对人体有害的瘀血通过专用工具排出体外的调理治疗方法。
通过排瘀疗法可以排出瘀血、清除毒素,净化身体内环境,加强全身血液供应,达到强壮体魄、防病治病的保健目的。
2、什么是瘀血?瘀血是人体毛细血管内不流动或者流动缓慢的血液。
不管是循环障碍性疾病,细菌感染性疾病,功能障碍性疾病等,实际上都是由瘀血引起的,也就是说最终疾病的原因都是血液循环不畅通导致的。
3、为什么会产生瘀血?外伤、细菌感染、肝肾功能障碍、环境污染、重金属防腐剂等化学物质、情绪压力等都会引起身体内瘀血。
4、哪些部位容易出现瘀血?有什么表现?局部发凉部位皮肤发黑、暗淡明显部位毛孔特别粗大部位经常皮肤僵硬、疼痛部位长出小疙瘩,黑斑,老年斑等色素沉着部位局部潮湿部位汗毛浓密部位5、是不是每个人都会有瘀血呢?是的,只要机体有新陈代谢,和外界接触,不管是外面的污染还是身体内部的原因,每时每刻都会导致产生瘀血。
6、为什么正常人和生病的人都要用排瘀疗法来调理?我们知道,不管是健康的人还是生病的人,在生活中身体无时无刻的都在产生瘀血。
瘀血是一种失去了新陈代谢能力的血,它们存在于人体的末梢循环毛细血管中,对人体没有益处,反而会影响正常的血液细胞。
随着年龄的增加和外界各种污染的加重,身体内的瘀血会越来越多,超出了身体自我化解的限度,细胞供血供氧就会不足,身体抵抗力下降而导致生病。
可以这么说,瘀血为百病之源。
所以,不管是病人还是健康人,身体内都存在瘀血,只是多与少的问题,都需要用泻血排瘀疗法来排出瘀血。

心天排瘀疗法心天排瘀疗法是一种传统中医疗法,旨在通过调理人体的气血运行,达到疏通经络,排除淤血,促进身体健康的目的。
在这篇文章中,我将详细介绍心天排瘀疗法的原理、方法和注意事项。
心天排瘀疗法是中医学中一种重要的治疗方法,它源于古代医圣张仲景的《伤寒杂病论》。
根据中医理论,病痛常常是由于气血运行不畅,导致经络堵塞和淤血引起的。
心天排瘀疗法通过调理人体的气血运行,疏通经络,排除淤血,从而促进身体健康。
心天排瘀疗法的方法主要有按摩、针灸和草药疗法。
按摩是指通过按压、揉捏等手法,刺激经络,促进气血流通。
针灸是利用针刺经络穴位,以达到调和气血的目的。
草药疗法是通过中药的药性作用,协助调理气血,清除淤血。
在进行心天排瘀疗法时,需要特别注意以下几点。
首先,病人应在合适的时间和地点进行治疗,以保证身心放松。
其次,心态要积极乐观,相信疗法的效果,有助于身体的恢复。
再次,治疗过程中要注意按摩或针灸的力度,避免造成过度刺激或损伤。
心天排瘀疗法有很多适应症,例如经络疼痛、跌打损伤、痛经等。
然而,对于某些疾病,心天排瘀疗法可能不适用,如严重的内脏疾病、感染性疾病等。
因此,在进行疗法前,最好咨询医生的建议。
心天排瘀疗法作为一种传统中医疗法,有着悠久的历史和丰富的经验。
虽然现代医学的发展已带来了很多新的治疗方法,但心天排瘀疗法仍然受到一些患者的青睐。
尽管它可能无法治愈所有的疾病,但它对于改善身体健康、缓解症状仍然具有一定的疗效。
总之,心天排瘀疗法是一种传统中医疗法,通过调理气血、疏通经络、排除淤血来促进身体健康。
它具有一定的疗效,并且适用于一些病症。
然而,在进行疗法前,应该咨询医生的意见,并遵循医生的指导进行治疗。
希望通过本文的介绍,可以对心天排瘀疗法有一个初步的了解。
以下是第二篇文章心天排瘀疗法是中医学中一种重要的治疗方法,它具有调理气血、疏通经络、排除淤血的作用。
在这篇文章中,我将继续向您介绍心天排瘀疗法的原理、方法和适应症。

泻血排瘀的基础知识“排瘀疗法”就是从人体内“瘀血”的观点出发,合乎逻辑地入手,把人体器官不能自行解决“清除瘀血”的难题,通过人为手段排出体外,恢复原有的生理机能为基本宗旨的。
“瘀血”,这一词语和排瘀疗法,是自古就有的,古埃及的壁画中就有拔罐的画面出现,所以,看起来其历史是相当悠久的。
但从实际内容看,可以说,那和我们的施术方法是完全不同的。
以当时的方法和技术条件,只能排出点鲜血,要把瘀血排出来,是不可能的。
排过瘀血的人都知道,用嘴吸法或用点燃酒精拔罐的方法,仅能放出一点鲜血,也仅能期望收到些临时性的疗效能。
把瘀血产生的根本原因和人体内存有多少瘀血,排掉瘀血为什么能治病等逻辑性原理讲清楚,并可以身体力行地用排瘀疗法治疗人体的50余种疾病。
也许有人不相信,仅用排瘀疗法就能把皮肤变白。
但,如果能按照指定的排瘀穴点排瘀,就能把相应的疾病一个个治愈。
万病之源在于瘀,人之所以疼痛的部位不同,患的疾病不同,就是因为不同的地方被瘀血堵塞。
把这些瘀血疏通,供血正常,病痛就会消失,人自然变得健康美丽!排淤时可以减轻患者的痛苦,而且还改进了罐的技术,由之前的火罐或者竹罐改成现在的橡胶罐,耐摔,吸附力强,而且方便清洗。
不同的穴位用不同的罐。
这样不但减少客户疼痛度,还增加了出血效果。
使治疗更加轻松和快乐。
刺血疗法又叫放血疗法,是中医的一种独特的针刺治疗方法,根据不同的疾病,用锋利的三棱针刺入穴位“络脉”(体表浅静脉),使之流出适量血液,达到和调气血、平衡阴阳和恢复正气的一种有效治疗方法。
刺血疗法源远流长,它的起源可追溯到新石器时代。
在现存的文献中,此法最早载于马王堆出土的汉帛书《五十二病方》中,其中曾有“引下其皮,以砭穿其旁”的记载,即是用砭石刺破皮肤来治病。
中医巨著《黄帝内经》的问世,使这一疗法发展到比较成熟的阶段,全书162篇,论及刺血疗法的竟多达40余篇,从理论到临床基本形成了一个比较完备的体系,其中对放血疗法的机理﹑施术部位﹑操作手法﹑适应症及禁忌症均作了精辟的论述,由此可见古人对刺血疗法治病具有相当深刻的以识。


心天排瘀疗法简介(一)心天排淤疗法是由韩国人朴楠羲先生经过几十年的研究创立的。
经十九年的临床证实:排淤疗法可治愈人体百分之九十以上的常见病和疑难杂症,是目前世界上唯一经过临床验证能够系统治病的自然疗法。
排淤疗法源于经络学、针灸、拔罐。
其理论是在向人体各个器官供血最易淤塞的51个部位,系统并针对性排出体内的寒滞及瘀血,使全身气血畅通,则向全身各个器官正常供氧和输送营养。
气血通畅了,各器官就能恢复正常功能,很多相应的病痛就会自然消失。
排淤疗法操作简单、见效快、治愈率高、治病彻底、不易反弹,且无任何副作用,是人人都能学会的自然疗法1. 瘀血学说肇始于《内经》,奠基于仲景;《内经》有血泣及恶血之论,仲景《金匮要略》有瘀血之命名。
万病根源在于瘀,人之所以疼痛部位不同, 患的疾病不同,就是因为不同的地方被瘀血堵塞,中医认为不通则痛。
把这些瘀血疏通,供血正常,人体各器官恢复正常功能,病痛就会自然消失,人自然变得健康美丽。
2.排淤疗法源于经络学、针炙、拔罐。
其理论是在向人体各个器官供血末端最易淤塞的51个通道上,系统并针对性排出体内的寒滞及瘀血,使全身气血畅通,则向全身各器官正常供氧和输送营养,气血顺畅了,各器官就能发挥正常功能,很多相应病痛就会自然消失。
经十九年的邻床证实:排淤疗法可治愈人体百分之九十以上的常见病和疑难杂症。
并且操作简单、见效快、治愈率高、治病彻底、不易反弹,且无任何副作用!是人人都能学会的自然疗法!中医采用各种手法和中草药活血化淤;西医采用对抗方式作用于已经产生的病灶甚至开刀手术;排淤疗法是另一种我们可以选择的自然疗法!瘀血:堆积在毛细血管中,堵塞血液循环不流动的坏死的血。
排淤:利用相关设备配合拔罐器,抽出坏死的瘀血。
(二)适应症:1.康复高血压、关节炎、手脚冰凉;各种胃肠炎、烧心、胃酸过多、食欲不振、消化不良;胃痉挛、腹泻、便秘、积食;劳累过度而引起的头疼、偏头疼、顽固性头疼;气喘、胸闷;慢性疲劳;各种脱发;视力减退、充血、眼压异常、遇凉风出眼泪等;风齿、牙齿怕凉等;黑斑、老年斑、脂溢性皮炎、小疙瘩;忧郁症、心烦意乱、心跳胸闷;健忘症、记忆力减退;噩梦惊醒、失眠;尿失禁、痛经、风寒、便血、月经不调;各种皮肤炎、白癜风、红血丝皮肤;皮肤特别黑的人;脚后跟皮肤开裂,脚气;腰、背、胳膊、腿酸痛;个别部位易出汗;各种气滞的现象,也就是通常人们所说的40岁肩痛50岁腰痛;浑身浮肿;感冒;癫痫病等等。

A2韩国心天泻血疗法--原理原理(2)一、成分学存在的问题我对西医也好还是中医也好,都没有进行过系统的学习。
只是通过媒体和纸面接触过,我对西医术语,细节到数据的表现,只能像计算器一样。
我只能在接触自然循环规律和人体生命现象的理论中,不断提出“为什么”,在与自然界的对比中寻找答案。
所以,就象对自然不能用数据取代一样,不能用数据罗列或细致的医学术语来描述。
所以,与搞基本医学的人士进行论理的话,发现有许多差异。
学习西方医学的人士,动员所有医学用语,对人体结构分的特别细,可以说深明事理也不过分。
再加上罗列的数据超越了人的想象。
可惜的是,内容太繁杂了,只能背出自己所学的东西,但在与人体有机结合上差距就太大了。
对出现的症状,连续问两个为什么,就无从回答了。
对高血压提出个问题试一试看。
血压升高的原因说的非常清楚。
但对产生高血压的原因提出两个为什么时,除此之外更多的理论解释就听不到了。
五行法,循环道理,都有重要的理由。
人体内各脏器、器官都以循环规律有机的连接着。
其中一个脏器发生故障,由此引起连锁反应,使其他脏器功能也下降。
肾脏功能下降,血液中尿酸的含量增多,这种状态若继续下去,肝的机能也会下降。
血液中尿酸过多,使血液混浊,是血液中缺氧的原因,相对使氮的含量增加。
这样使细胞活动迟钝,不能使营养成分转化为能量释放,使血液变稠,阻碍血液流通,由此使尿酸增多,形成恶性循环。
这个过程引起肥胖,肝功能必然下降,肝功能下降使血液中的毒素增加,其合并症使血液中的瘀血增加,这是中风、关节炎、甲状腺、人体内各种肿瘤产生的原因。
瘀血在2号胃肠穴、3号根穴容易积聚,影响其消化吸收功能,脸上易生黑斑,6号高血压穴瘀血过多,会形成高血压,5号心绞痛穴瘀血过多,会产生低血压或心绞痛。
随着瘀血堵塞血管的位置不同,其疾病的名称不同。
不用这样理论对各脏器有机的联系起来进行解释,是无法找到答案的。
无视这个过程,分别对血液和各脏器进程血检,会得出肾脏没有问题,没有浮肿,没有炎症,一切正常的结论,不顾因血液中尿酸含量增加,引起的肾功能下降的这一事实。

心天泻血疗法讲义新‘心天泻血疗法讲义一、概念(一)、血液清净可除万病:人体疾病依产生的原因不同,可分为循环障碍性疾病,细菌感染性疾病,功能障碍性疾病等等。
但实际上都是瘀血性疾病,也就是说最终都是瘀血循环不畅而导致的疾病。
泻血可以帮助净化血液,只要血液清净,病可不治而愈。
(二)、瘀血:中医把坏死的血液看作是瘀血,泻血理论认为:附着在毛细血管中不流动的血叫瘀血。
(三)、瘀血生成的原因:农药,防腐剂等有毒化学物质的堆积;重金属累积;来自社会和生活的双重压力;肝肾功能的下降等。
(四)、泻血:利用拔罐器,抽出瘀血。
(五)、为什么要泻血?自然界的规律就是随着年龄的增长,堆积在体内的瘀血越来越多,同时人体自身净化瘀血的能力又越来越弱,加之自身年龄百分比,就是人体的瘀血所占的比例,瘀血会导致人的衰老,死亡。
泻血还能还您原有的健康和美丽。
二、泻血适用范围:(一)康复:高血压、高血脂、高胆固醇、低血压、肝炎、脂肪肝、心胶痛、烧心、中风、胸口烦闷、烦燥、各种脱发;视力(视力减退、充血、眼压异常、遇凉风出眼泪等);风齿、牙齿怕凉等;黑斑、老年斑、脂溢性皮炎、小疙瘩;胃肠疾病(胃肠炎、胃酸过多、胃痉挛、厌食症、消化不良、腹泻、便秘等);口臭、痔疮、手足冰凉、风湿性关节炎、糖尿病;痛症(劳累过度而引起的头疼、偏头疼、顽固性头疼、肩颈疼、腰疼、神经疼等)静脉曲张、脚气、尿失禁、痛经、便血、月经不调、自然流产;各种皮肤炎(白癜风、红血丝皮肤;皮肤特别黑的人);感冒、鼻炎、咽炎、哮喘、扁桃体炎、失眠、忧郁症、癫痫病、痴呆、慢性疲劳、前列腺炎。
(二)保健:经泻血身体康复后,即身体的各项功能恢复到与生惧来的健康状态时,进入保健期。
(三)美容、美体、生发、美发1、美容:提升上眼脸、消除下眼脸浮肿(眼袋)、消除粉刺、祛斑、白晰皮肤、缩小毛孔、淡化鱼尾纹、收紧双下巴、瘦脸。
2、美体:丰胸、收紧皮肤、细腿(大、小腿)、减肥。
3、生发、美发三、泻血部位:心天泻血部位,是以中医经络理论为主导,以韩式泻血疗法为基础确定的51个部位。

排瘀疗法综述自然排瘀疗法——世界上根治疾病最好的方法排瘀疗法综述自然排瘀疗法——世界上根治疾病最好的方法一、排瘀疗法排瘀疗法是由韩国朴楠羲先生经过二十多年的研究创立的新型医疗手段。
它既不是西医,也不是中医,属于另类医学。
其理论是向人体各个器官供血末端最易瘀塞的51个穴位上,系统并针对性排除堵塞在毛细血管里的淤血,使血脉畅通。
他认为万病之源是血液循环不畅,血液循环不畅的理由是因为瘀血堵塞了毛细血管,只要清除了瘀血,使血液循环畅通,就没有病痛和死亡的理由。
不幸的是,我们的身体随着年龄的增长,逐渐出现了血液循环障碍,不能向全身各器官正常供氧和输送营养,使各器官的功能与人体免疫力逐渐降低,导致持续老化,最终产生各种疾病。
二、什么是瘀血,瘀血则是指死的血或堆积在毛细血管上不流动的血。
瘀血有两种,一种是一出体外,立刻凝固成果冻状;另一种是糖稀状的粘稠物,时间长了会化解成像水一样的,这样的瘀血排出时像水一样流速很快,但因血色呈黑色,一眼就可判断出是坏死的血。
三、瘀血是怎么产生的, 肾功能低下肝功能低下重金属的累积化学物质堆积跌打磕碰因各种毒性物质,造成白血球的尸体堆积精神压力过重等等四、什么是排瘀疗法那么,引起血液循环障碍的直接原因是什么呢,其实就是瘀血的产生和瘀血量的增加。
什么是排瘀疗法,排瘀疗法就是从人体内的瘀血的观点出发,合乎逻辑地人手,把人体器官不能自行解决“清除瘀血”的难题通过人为手段排除体外,恢复原有的生理机能为基本宗旨的。
经20多年的临床证实,排瘀疗法,可以治愈人体80%以上的常见病和疑难杂症。
并且操作简单,见效快,治愈率高,治病彻底,不易反弹,且无任何毒副作用,是人人都能学会的自然疗法,绿色疗法。
五、为什么要排瘀, 瘀血停留的地方是毛细血管,大多数瘀血并不沿着血管流动,而是粘附在毛细血管内。
就像江水虽然流动,但沉淀的泥土是不留动的,“把这个沉淀的泥土看作是瘀血,那么江是血管,在上面继续流动的清水是新鲜血液”。


序言(1)自己的病要自己治我写这本书之前,曾考虑过许多问题。
我的医学理论与现在传统观念的医学理论有着很大差距,从现实的角度来看会有多少人能接受?想到这些也有些犹豫。
但是,无论如何总得有人普及一个合乎道理的正确的医学理论,尤其是当我看到那些受疾病折磨而痛苦不堪的人的时候,我觉得不能再犹豫了。
所以虽然我对微机有些生疏,但下定决心跟电脑打一番交道。
看一看近来新闻媒体的报道,就可以知道医学技术有日新月异的发展(?),医学设备也达到惊人的程度。
但是据最近的新闻报道,我国国民人均西药消费量是世界第一位。
请细心地观察一下您周围的人们,在一个家庭中究竟有多少人是健康的呢?看一看整个国民的健康状况,就更加令人担忧。
这样的现实暗示我们什么呢?医学技术建立的宗旨是为了治病,那么,人们将随着医学的发展相应地更加健康起来,随着使用药量的增加也相应地更加健康起来才是。
然而不幸的是,现实与此完全相反,如果如此发展下去,整个国民变成患者的日子已为期不远。
即使这样,现在也决不能放弃对疾病治疗的努力。
全世界有许许多多的高级志士仁人,正为解除疾病的痛苦而不懈地努力奋斗着。
那么产生这种巨大矛盾的根本原因在哪里呢?虽然有那么多的人不断地为解决疾病问题而努力,但是实际上,医学技术的发展远远跟不上人们健康的需要,这不正是从反面证明已有的医学技术在理论和道理上存在着很多问题吗?这是因为,并没有把整个人体理解成一个有机整体,没有把疾病按着起因有机地联系起来解决,而是把身体分成一部分一部分,企图用局部地解决所造成的,其结果只能是事倍功半,付出许多,收效甚微。
如果让我评价现代医学技术,我就可以断然:他们是把答案握在自己手中却不知道答案在哪里。
为什么这么说呢?因为虽然现代医学已经高度发达,可以把人体各部分用生理学、分析学、解剖学解释得很清楚,但是在实际治疗手段方面却没有取得任何值得满意的成效。
如果让我把我的医学技术和现代医学技术做个比较,由于我不采用手术方法,所以我不想涉及方面的问题,在因循环系统的障碍引起的疾病方面,我能够胸有成竹论述的部分是很多的。
泻血的实际一、泻血前的准备(一)诊断方法(寻找瘀血的部位)只要我看到患者,就能准确无误地观察出此人哪个部位有瘀血 , 不必利用任何机械或仪器,只通过视觉和手的触觉就能判断。
不懂泻血疗法原理的人,可能会提出这样的疑问,人是看不见体内隐藏瘀血的,可又如何知道瘀血在哪里呢?实际上懂得了人体的原理,又懂得了瘀血障碍所引起的症状,就能知道瘀血在何处了。
血液循环不畅的直接原因是瘀血堵塞了血管,反过来,凡是有瘀血的部位,血液就不通畅。
对于血液循环不通畅而产生的现象,只要从反面进行推理,就能获悉瘀血的部位。
因血液循环不畅而产生的现象,可从以下几个方面来观察:◎局部发凉◎局部皮肤发黑◎毛孔粗大◎皮肤僵硬◎局部潮湿◎身上的汗毛特别浓密◎局部长出较多的小疙瘩或黑斑,老年斑等这些现象任何人都能看得出来,那么下面对这些现象作一下详细的解释:◎局部发凉:血管被堵塞,血液循环不能正常进行,所以此部位会发凉。
◎局部皮肤发黑:正常条件下细胞的寿命是45天。
那么皮肤发黑是什么原因呢?这是因为老化的细胞过于集中造成的。
老化的细胞过于集中又是由于血管被堵塞,不能及时供应营养,细胞不能进行正常的新陈代谢而造成的。
也就是说45天的周期内未能及时进行新陈代谢。
◎毛孔粗大:毛孔粗大的部位就是平时出汗多的部位,而出汗多的部位平时都是易发凉的部位。
造成局部发凉是由于血液循环不流畅,而造成血液循环不畅还是由于瘀血堵塞血管引起的。
◎皮肤僵硬:皮肤之所以僵硬,是因为细胞缺氧而处于窒息的状态。
供氧和供血应该是相互配合进行的。
血液供应受阻,氧气的供应自然也会受影响。
◎局部长出很多小疙瘩、黑斑、老年斑等:长出小疙瘩是说明此部位有炎症。
白血球是能够杀死炎症的,但因血管被堵塞,白血球又无法移动至有炎症的部位。
血管的堵塞是由瘀血引起的, 所以,有小疙瘩的地方就是有瘀血的地方。
黑斑的产生请参考第二项。
◎局部潮湿:局部潮湿的部位当然也是发凉的部位,发凉是由于血液循环不畅,那么引起血液循环不流畅的原因当然也应是瘀血了吧?◎身上的汗毛特别黑浓密:此内容请参考头痛与脱发篇。
应急治疗〈应急治疗〉篇是介绍在危急状态下,只进行1-2 次就能见效的泻血点。
只进行一次泻血也可以见效,但为了保证不再复发,就必须要按我所讲的泻血基本方法泻血。
泻一次血,只要见点血就能脱离危险。
· 胃痉挛、急滞食、心脏麻痹:对2 号、30 号穴位泻血。
· 突发性高烧和血压高:只有血压升高时6 号泻血,同时伴有高烧时6 号、8 号、1 号同时泻血,同时把竹盐放在嘴里用唾液溶服,这样高烧和血压会马上降下来。
·头疼严重时:1 号穴位。
· 血压升高头痛时:6 号穴位泻血。
同时伴有发烧现象时,也对8 号穴位也泻血。
· 脚气:泻血的特效穴位是26 号、27 号穴位。
因脚气有发痒现象时直接对发痒部位进行泻血。
· 中风:对6 号、1 号、9 号穴位与手指尖进行针刺放血。
· 感冒初期:对4 号、18 号Q :现代医术把高血压当成不治之症,只能让患者吃药,一直吃到死,那么心天泻血疗法能治好此病吗?A :可以。
只对高血压一种症状来讲,还算不上什么病,很容易治疗的。
问题在于产生高血压的原因。
高血压的直接原因是瘀血堵塞了血管,那么只要把瘀血泻出,把堵塞了的血管疏通,让血液循环畅通病就治好了。
但是,血管被堵塞,已达到出现高血压,其他器官也不可能是完好无损的。
对肾功能下降,肝功能下降等症状如果不同时进行治疗,是随时都有复发的可能性。
只进行降血压处理,是一种治表不治本的方法。
我对医术所做的说明,没有拿出更多的数据,只讲理论因而感到有些遗憾。
但理论是道理,道理是常识。
我想脱离道理和常识的医术是不存在的。
高血压既是一种常见的疾病,又是一种慢性病。
高血压是我最着急的,也是对其治疗最不满意的一种疾病。
特别是近些年来,我们周围患这种病的人特别多,是顽症中的一种。
单纯性高血压这一种症状来讲,可以说是谁都能治的一种疾病。
如果不能及时治疗,病情恶化就会导致合并症,最终发展成糖尿病或中风。
自然排瘀疗法——世界上根治疾病最好的方法自然排瘀疗法——世界上根治疾病最好的方法从人体结构上讲,只要血液循环畅通,我们的身体就不会生病,也不会死亡。
随着年龄的增长,身体开始老化,肝肾等脏器功能衰竭,血栓阻塞血管,血液循环不畅,造成高血压、心脏病、头痛、腹痛、颈椎病、腰腿疼、关节炎等疾病。
疾病的差异只是在于血栓阻塞的血管位置不同。
人体最大的弱点是随着年龄的增长,自身无法消除逐渐增多的血栓。
自然排瘀疗法就是人为地消除人体自身无法消除的血栓,使血液循环畅通,恢复原有的脏器功能。
血液中毒素达1000多种,而70多种疾病与血毒有关。
我们现在吃的食物中很多都有农药残留成分、防腐剂、还有重金属化学物质污染。
这些都严重危害人们的身体健康。
癌症的发病率也越来越高。
而人们却从未想到要消除产生疾病的根源,那就是使我们的血液清净。
只要血液清净、血液循环畅通了,就不会得高血压、糖尿病、中风甚至老年痴呆症等疾病。
血液清净,万病可除。
中医讲不通则痛,血液不通,血液到达不了的地方就会造成局部细胞缺乏营养,而细胞缺乏营养便会产生病变、死亡,从而形成堵塞血管的淤血。
淤血就是血管中粘附的不流动的、坏死的变成垃圾的血。
越是寒冷阴雨天气血管堵得越严重,就更加疼痛,这便是颈肩腰腿痛等各种疼痛疾病产生的原因,更是各种慢性疾病的主要诱因。
自然排瘀疗法也叫刺血疗法、净血疗法、泻血疗法。
它是在中医基本理论指导下,采用专用工具、利用负压原理,在人体末端毛细血管最易瘀阻的病变部位排出淤血、寒滞和毒素,使血液清净、气血循环畅通,再通过强化供给细胞营养,各器官就能得到修复,增加造血功能,从而改变人体内环境,把五脏六腑调理平衡,从而达到根治疾病的目的。
自然排瘀疗法是世界上根治疾病最好的方法。
它源于中国中医针灸刺络疗法,它历史悠久、源远流长,而且广泛流传于民间。
刺血疗法在国外也得到广泛应用和发展。
1969年5月15日,日本人黑岩东五出版《真空净血疗法》一书;1991年韩国人朴南羲出版《心天泻血疗法》一书。
排淤治疗高血压的原理是什么呢?(上)现代医术把高血压当成不治之症,只能让患者吃药,一直吃到死,那么韩心天泻血疗法能治好此病吗?可以。
只对高血压一种症状来讲,还算不上什么病,很容易治疗的。
问题在于产生高血压的原因。
高血压的直接原因是瘀血堵塞了血管,那么只要把瘀血排出,把堵塞了的血管疏通,让血液循环畅通病就治好了。
但是,血管被堵塞,已达到出现高血压,其他器官也不可能是完好无损的。
对肾功能下降,肝功能下降等症状如果不同时进行治疗,是随时都有复发的可能性。
只进行降血压处理,是一种治表不治本的方法。
单纯性高血压这一种症状来讲,可以说是谁都能治的一种疾病。
如果不能及时治疗,病情恶化就会导致合并症,最终发展成糖尿病或中风。
对这种现状,现代西医治疗高血压的药物中,含有神经安定剂,是一种麻醉剂,长期服用会产生副作用,是导致第三种疾病的原因。
长期服用高血压药物的患者,如果突然发生体重增加的情况,那么就预示着中风或糖尿病发生。
虽然是为了治疗高血压而用的药,但知道了这种药进入到人体以后是什么样的药理作用,使高血压降下来的道理,就能明显地看到,导致中风是必然的。
任何人都可能患高血压。
那么根据何在?从人体结构上看,身上没有瘀血的人是不存在的,如果人体本身具有化解瘀血的功能,我们就不会得病,也不会因病死亡。
人身上的瘀血,随年龄逐渐增多,如果从人体原理上讲,这些瘀血若分散在不同的部位置,那么即使这些瘀血把50%的毛细血管堵塞了,也只能感到有些疲惫、发沉。
高血压在初期阶段,瘀血是堆集在6号高血压穴位上的,这时只要对6号进行泻血治疗就能治好,如果治疗方法不得当,就能引发综合症,治疗所需要的时间也要相对延长。
高血压要从字面上理解,就是血管内血液的压力增高的意思。
这样看起来,其治疗方法应该是消除血压增高的原因。
但现实并不是这样的,举个例子看,把一个长胶皮管看作是血管,那么在用抽水机抽水的时候,有阻力的情况下和没有阻力的情况,会出现什么样的差异呢?胶皮管被堵塞,内部压力增高的时候,要想使水顺利流通,就必需把堵塞的地方疏通。
心天排瘀疗法的理论依据
心天排瘀疗法的理论依据(2012-03-11 21:17:05) 标签:泻血疗法
血液
瘀血
血管
万病之源在于淤,人之所以疼痛的部位不同,患的疾病不
同,就是因为不同的地方被淤血堵塞 .把这些淤血疏通 ,供血正常,
病痛就会消失 ,人自然变得健康美丽 ~!
一、概念
(一)血液清净可除万病人体疾病依产生的原因不同,可
分为循环障碍性疾病,细菌感染性疾病,功能障碍性疾病等
等。
但实际上都是瘀血性疾病,也就是说最终都是瘀血循环
不畅而导致的疾病。
泻血可以帮助净化血液,只要血液清净,
病可不治而愈
(二)瘀血瘀血=在毛细血管里不能流,被堵住的垃圾、血液残留物像在下水道或排水口堆积起来,阻碍水流或
完全堵住水流的那种残渣一样的东西。
和现代医学中所
说的血栓或胆固醇,在概念上完全不一样。
①100% 鲜血 (= 干净的血 )——不成块容易被棉花所
吸收。
②瘀血大约是 15% ——瘀血发暗,不能被棉花所吸收,像是粘胶块。
③瘀血大约是 80% ——在火炉前面也不能溶化,像强力胶一样粘粘的。
所谓的淤血,就是指阻碍血流的血液中残渣(=血液垃圾),是堵住毛细血管停在那里不流动的垃圾。
一旦毛细血
管的一个地方被堵住,流在其前、后的血液都会停止流动。
就这种状态下过些时间就会变成死血,随着岁月的流逝颜色
越来越变黑,量越来越多。
肾脏或肝脏瘀血多的话,不能过滤老废物或毒素,血液
污染会更加严重,体力下降或引起各种疾病,使瘀血更加快
速增多。
想使血液一直保持清澈的的话,应该要把主要脏器
的瘀血去除。
(三)瘀血的发生原因
瘀血的发生原因——原因也许很多,下面只看几种代表
性的原因。
公害、农药、不良食品——被污染的空气或水里所含的
重金属或化学物质的摄取,使血液受到污染产生淤血。
农药
是了死害虫而生,但它能同死、蝌蚪、蚯蚓、牛、金、⋯⋯同的道理,抗生素不光死病菌
死人体内有益的微生物和白血球使它成淤血。
去除淤血包
括去除体内的重金属(毒品)。
菌入侵——入到体内的菌被抗生素等死的,成尸体到
漂流着漂流着,互相粘在一起堵死毛血管成淤血。
力——促使很多淤血的生成。
力使血管收,使好不容易
通毛血管的混的血液停止流,停止流的血液生反又使
其它的血液停止流。
就血液停止流的状下一段血液以
再流,成永的淤血停在那里。
受到力的人老得快,理由
也是因。
怒一次,老一次,笑一次,年青一次的也是因。
吸烟(烟)——吸烟人体有害是因两种原因。
第
一,尼古丁一方面染呼吸系(支气管、肺)癌症一
方面入血管染血液,生癌症的原因也是因血液循
不好。
第二,烟和尼古丁刺激肺里面的毛血管(肺泡)使
毛血管反射性(拒反)地收,阻碍入到肺里面的
氧气送,上引起痛或体胞由于氧气不足,没法
新代(氧化作用),更加生淤血(垃圾)。
所以吸烟不
只肺癌,成所有癌症生的促。
烟除了肺癌以外
可引起其它癌症,在美国医学上已被。
和肝功能的减退——血液内像尿毒一的和代物
的,和起解毒作用的肝功能减退,血液快速被染残留物被
累堵住毛血管。
果引起数百种可怕的并症。
各种物的服用及注射——代人不得不吃被自身开的
染的品,有无可奈何地接受代医学开的抗生素、防腐、
痛(=麻醉)到体内。
是防止食的腐和治眼前的病不得
已的事情,但些都是染血液的可怕的毒品。
些物人体有
害的原因就是因染血液生淤血。
打或口——脚脖子扭或被虫子或毒蛇咬或瘀
青⋯⋯生很多淤血(=坏血)。
有淤血青或的地方,些瘀血被散开,只不是些地方已有的坏血(=死血)或毒性成份移到的地方而已。
和肝可以把它的一部分消除,但大部分作淤血被堆在体内。
牛肉等和脂肪——有不少人,用和脂肪、不和
脂肪的用明不好理解。
用的明的,
都会有的,煮好的牛肉或牛放凉了之后⋯⋯
浮在上面的牛油就算是夏天也会凝固,但不是牛肉的其它的
像猪肉、肉、肉、等的油,不是寒冷的冬天不容易凝固。
所
以牛肉的脂肪在我身体里也容易凝固堵住毛血管,成肥胖
和淤血增加的原因。
像猪肉或肉等有程度上的差异,但吃
多了都不好。
那么植物油(香油、豆油、玉米油、橄油等)怎么
呢?成冰的冷室里也不凝固。
可是份取,就会脂肪乘,当
然身体有害,特是外面的油炸食品很不好。
速熟食品不好
的理由也是一。
被染的口白面也最好是避免。
不只是牛肉有羊或兔子等草食物基本上都是一的。
相来食物(猪、子、狗⋯⋯)一些。
不癌症患者吃的也是像
牛肉的。
可是自然吃
了也不妨。
物油中油最安全。
是吃的(、刀、金等)比好。
吃牛肉多的美国,都到了可以成一肥胖患者的集合体
的程度,吃比多的日本人肥胖患者比少,不吃牛肉的印度,可以成根本没有肥胖患者的程度。
可是白米和白面吃得
多也有小肚子鼓出来。
如果一定要吃肉的,(煮一煮)把和脂
肪底清除后再吃。
瘀血的种—— 3 种
淤血的种看得大一点就一种。
阻止血液循的血都
是淤血。
如果按阻止血液循的方式或形上分的如下三种。
瘀血=堵住毛血管的垃圾、血液残渣、粘硬的血
1.不容易通毛血管的粘的淤血
取牛肉、猪肉等脂肪成份多引起高血脂症(=硬的
血)或血液中各种染物或异物增加,随着的推移些地和血粘在一起形成或成粘粘糊糊的状,通毛血管的候速度非常慢,就像从一个小胡同里破的大型卡通⋯⋯使得跟在后面的好血,也受到阻碍不能正常流。
种硬的粘粘糊糊的血没有,身体更有利。
色
和正常的血液差不多。
2. 毛血管里被堵得的黑色的淤血
你有没有眼目睹黑色的淤血在主要的器里装得的?上会看到的。
粘粘的淤血通毛血管的候某种原因停止流。
那理由有无数种,其中一个例子的,(特是妊娠女)睡的候,性地把右胳膊在身下睡的,右胳膊被得血液不容易流。
特是好不容易通里的粘粘的淤血被停止流的状下,一夜后,干脆凝固在那里。
不采取特措施的,随着的推移越来越凝固,失去了作血液的价。
使就跟在后面的血液也停止流使其失血液的功能,有其它的淤血也粘在
一起限制周,使淤血的模越来越大。
感有点疼或不舒服,
按摩一下好像好了点,但血液又重新瘀在那里,疼痛或不舒
服的感会反复生。
随着的流逝淤血越来越大越来越硬,
色越来越黑。
越是那疼痛越加大,
以后展成肩膀和胳膊以的程度。
到种程度,... 合医院也好都不能治。
不能。
无怎么化小便和血液
找不到原因。
用MRI 、CT 、X 也不出来。
是个肩膀的例子。
如果个地方不是肩膀,是的
⋯⋯是肝的⋯⋯是心或的⋯⋯真是可怕的
事情。
也不需要明,用泻血法上能解决。
3. 像墨水一的淤血
停在毛血管的状下大10 ~20 年成黑
暗的色。
个再20 ~30 年成黑黑的并化成水。
就像墨水⋯⋯种人大部分都是60 以上,有重的痴
呆、健忘症、痛的人的里面也有的淤血。
其中最常的情况
就是痴呆和中患者。
如果你眼看就像墨水一的血液的⋯⋯
会明白一个人的泻血法什么
...秀的理由。
像化成墨水一的淤血已成和水一了,和血液一起流
才,但什么不能流被堵在那里呢?也想想人体内立体性
分布的毛血管的构造,就容易理解了。
如果毛血管里有一个
停止流的淤血,那么想流那周
的其它粘粘的淤血块粘在那上面或堵住周边的状态下经过
20 ~ 30 年的时间,淤血块(规模)变得越来越大。
其中停
流时间最长的中心部分先变硬变黑。
再经过20 ~ 30 年,那外围部分的淤血也变黑变硬。
最中心的淤血经过40 ~ 60 年变软成为像墨水一样。
可是经过20 ~ 30 年时间变黑变硬的淤血围绕在其周围堵住了它,所以中央变成和墨水一样的淤
血不能流,一直停流在那里。
如果亲眼看到60 岁以上的老人头脑里有这样的墨水,真正能体验到中风、痴呆等人生末
期病为什么来。
这种墨水放在那里不管,避免不了头痛、痴
呆、中风等。